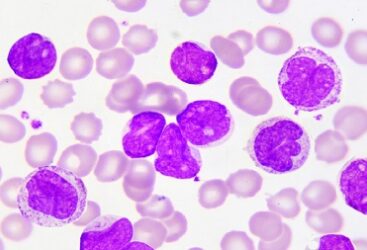
France: Une Nouvelle Avancée dans le Traitement de la Leucémie Myéloïde Aiguë.

Mettre son parfum au congélateur : une bonne idée pour le faire durer plus longtemps ?
Avez-vous déjà entendu qu’il serait bénéfique de conserver son parfum au congélateur pour prolonger sa durée de[...]

Avez-vous déjà entendu qu’il serait bénéfique de conserver son parfum au congélateur pour prolonger sa durée de[...]

Symptômes et Gravité. La fièvre d’Oropouche, dont les symptômes rappellent ceux de la dengue, a récemment[...]
Caractéristiques Génétiques et Métaboliques des Cellules Souches Leucémiques. Des chercheurs ont fait une déco[...]

L’Ass L’Association de Multimédia et de l’Audiovisuel (AMAVI) a le plaisir d’annoncer la signature d&rsqu[...]

Conçu par Jean Nouvel, le dernier et le plus grand espace éphémère parisien de Samsung ouvrira ses portes aux fans des [...]

Grâce à la nouvelle Galaxy Ring, ainsi qu’aux Galaxy Watch7 et Watch Ultra, les utilisateurs sont désormais en mesure [...]